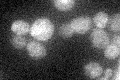
YKR044W
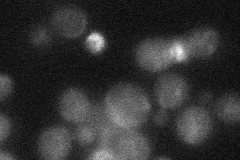
YKR044W

View description
Protein of unknown function that interacts with Ulp1p, a Ubl (ubiquitin-like protein)-specific protease for Smt3p protein conjugates
Localization:
Intensity:
Fold change:
Significance:
-
C’ GFP library in SD
ambiguous21.24 -
N' NOP1pr-GFP in SD

punctate,vacuole48.1963 -
N' TEF2pr-mCherry in SD

vacuole25.364 -
N' NATIVEpr-GFP in SD
below threshold20.5185 -
N' TEF2pr-VC and Cyto-VN in SD

#N/A0 -
C’ GFP library in SD+DTT

ambiguous20.750.97No -
C’ GFP library in SD+H2O2

ambiguous20.990.98No -
C’ GFP library in Starvation Media

ambiguous17.70.83No -
C’ GFP library on the background of Pup2-DaMP

ambiguous -
C’ GFP library on the background of CCT mutant

ambiguous23.19121.09166No
